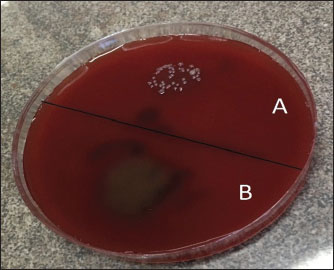

| Research Article | ||
Open Vet. J.. 2025; 15(10): 5202-5220 Open Veterinary Journal, (2025), Vol. 15(10): 5202-5220 Research Article Histopathological and ultrastructural evaluations of giant African snail (Achatina fulica) mucin and alginate hydrogel on cutaneous wound healing in ratsMohammad Reza Salahi1, Mohammad Mahdi Molaei1, Shahrzad Azizi2*, Pourya Mohammadi3and Maziar Jajarmi21Department of Clinical Sciences, Faculty of Veterinary Medicine, Shahid Bahonar University of Kerman, Kerman, Iran 2Department of Pathobiology, Faculty of Veterinary Medicine, Shahid Bahonar University of Kerman, Kerman, Iran 3Department of Chemistry, Shahid Bahonar University of Kerman, Kerman, Iran *Corresponding Author: Shahrzad Azizi. Department of Pathobiology, Faculty of Veterinary Medicine, Shahid Bahonar University of Kerman, Kerman, Iran. Email: azizi [at] uk.ac.ir Submitted: 30/06/2025 Revised: 09/09/2025 Accepted: 18/09/2025 Published: 31/10/2025 © 2025 Open Veterinary Journal
AbstractBackground: Wound healing is a complex biological process that involves inflammation, cellular proliferation, and tissue remodeling. Efficient and prompt wound repair is critical for infection prevention and tissue integrity restoration. Snail mucin contains glycosaminoglycans, proteoglycans, and growth factors that promote fibroblast migration and extracellular matrix formation and reduce inflammatory reactions. Alginate hydrogel, a biocompatible polysaccharide, creates an ideal wet microenvironment, promotes hemostasis, and aids in cellular infiltration and growth. Aim: This study aimed to investigate the effects of snail mucin 96%, alginate hydrogel, and their combination on cutaneous wound healing in a rat model. Methods: Sixty adult rats were randomly divided into five groups (n=12 each): negative control (no treatment), positive control (zinc oxide ointment 25%), alginate hydrogel 2%, snail mucin 96%, and mucin-containing alginate hydrogel 1% (Al-Mu). Wound contraction was measured on days 0, 3, 7, 10, 14, and 21. Histopathological assessment was performed on days 7, 14, and 21. Ultrastructural investigation was also performed on day 21. Results: The snail mucin 96% and Al-Mu 1% groups showed considerably faster wound closure, better histological characteristics, and full healing by day 21. The average percentage of wound contraction was greater than that in the other groups (100%). Healing in the 2% alginate hydrogel and 25% zinc oxide-treated 25% groups was comparable but not as effective as that in the snail mucin-treated groups. The alginate hydrogel group had an average wound contraction rate of 98.78% ± 0.87%, while the zinc oxide-treated group had a rate of 95.38% ± 0.62. The no-treatment group had the lowest healing rate (71.58% ± 9.49%). Conclusion: Snail mucin, either alone or combined with alginate hydrogel, considerably improves wound healing, resulting in full closure and better tissue regeneration by day 21. The mucin-treated groups outperformed the alginate hydrogel and zinc oxide-treated groups, demonstrating the powerful healing effects of snail mucin. These findings show that snail mucin-based therapeutics could be a potential approach to accelerate wound healing and increase tissue restoration. Keywords: Cutaneous wound healing, Giant African Snail Mucin, Achatina fulica, Alginate Hydrogel, Rat. IntroductionThe skin is the largest organ in the body and plays a crucial role in the maintenance of life. It protects the body from damage and microbial invasion and maintains body fluid, electrolytes, and nutrients (Zhang and Zhao, 2020). A wound is defined as a disruption of skin integrity because of any trauma, either intentional (surgical incision) or accidental (Oliveira et al., 2012). When a wound occurs in the body, physiological healing occurs through multiple bio-cellular and biochemical processes. Wound healing refers to the process by which normal tissue is regenerated from damaged tissue (Rosanto et al., 2021). The healing of any wound generally involves four stages: hemostasis, inflammation, proliferation, and matrix formation or remodeling (Rivera and Spencer, 2007). This process can be observed using several parameters, such as re-epithelialization, the number of polymorphonuclear leukocytes, fibroblasts, collagen fiber density, and angiogenesis (Van Der Laan et al., 2009). The ultimate goal of wound healing is the restoration of normal skin function, a highly organized process that includes various phases and multiple growth factors acting in a coordinated manner at the correct time and sequence to restore epithelial integrity (Bernabe et al., 2023). Chemical and natural treatments can enhance wound healing (Sivamani et al., 2012). Snail mucin is a lubricant widely recognized for its antibacterial, antiaging, antifungal, therapeutic, wound healing, and cicatricial properties (Dhiman and Pant, 2021). It is composed of glycosaminoglycans, hyaluronic acid, collagen, elastin (Dhiman and Pant, 2021), achacin (Etim et al., 2016), heparan sulfate (Rosanto et al., 2021), and acharan sulfate (Das et al., 2022), which act as humectants and are potentially beneficial for anti-bacterial properties (Etim et al., 2016) and promoting angiogenesis (Rosanto et al., 2021). This natural product contains proline, serine, asparagine, glycosaminoglycan, hydroxylysine, and trionin, among others, to activate the growth factors (Rahmawati et al., 2014). Mucin extraction methods are generally categorized into two main types: invasive and non-invasive. In the invasive method, mucin is extracted from the soft tissue of the snail’s body using special methods after breaking the snail’s shell. Non-invasive methods, which are safe and harmless to snails, are divided into two categories: solvent and mechanical methods (Das et al., 2022). In addition to protection and isolation, wound dressings accelerate wound healing for both acute and chronic types and reduce infection by promoting collagen synthesis, re-epithelialization, creating a hypoxic environment, and decreasing wound bed pH. Modern wound dressings, such as foams, hydrocolloids, and hydrogels, have been developed with advancements in medical care (Zhang and Zhao, 2020). Hydrogels could be produced by the physical or chemical cross-linking of natural and synthetic hydrophilic polymers. They are ideal dressings because of their non-adhesive nature, malleability, and similarity to living tissue (Francesko et al., 2018). Hydrogels can donate water to the wound site and maintain a moist environment for cell migration, accelerating wound healing (Yoshii et al., 1999). Alginate is a linear anionic polysaccharide extracted from brown algae or bacteria, consisting of repeating units of β-1,4-linked D-mannuronic acid (M) and L-guluronic acid (G) in varying ratios (Zhang and Zhao, 2020). Alginate could be synthesized by several bacteria, but all commercially available alginate is produced from brown algae extraction. Na-alginate is the most widely used alginate salt (Zhang et al., 2021). Alginate biopolymer has been used in the design and development of several wound dressing materials to improve wound healing efficiency. Alginate’s hydrophilicity, excellent biocompatibility, and high liquid absorption capacity make it an attractive material for wound dressings (Varaprasad et al., 2020). Alginate can activate macrophages and stimulate monocytes to produce interleukin-6 and tumor necrosis factor-α (TNF-α) to accelerate chronic wound healing (Thomas et al., 2000; Yang and Jones, 2009). Alginate-based wound dressings can be applied in the form of hydrogels, films, foams, nanofibers, membranes, and sponges (Zhang and Zhao, 2020). Alginate hydrogels can be prepared using several methods, including ion interaction, covalent crosslinking, thermal gelation, and cell crosslinking (Zhang et al., 2021). The physical and chemical properties of alginate hydrogels can be tailored for various biomedical applications by altering the type and density of crosslinking. Ionic crosslinking with multivalent cations is the most common method of alginate gel formation, which can be performed under mild conditions (Sun and Tan, 2013; Zhang et al., 2021). Calcium salts suitable for alginate crosslinking include calcium chloride (CaCl2), CaSO4, CaCO3, calcium acetate, and calcium ascorbate (Kuo and Ma, 2008). Numerous studies have reported the use of Ca2+ as an ionic agent to prepare alginate-based hydrogels (Chen et al., 2002), with the main limitation that the formed gel will disintegrate in a physiological environment (Zhang et al., 2021). In consideration of the aforementioned findings, the current study was conducted to assess the effectiveness of mucin and alginate hydrogel in promoting cutaneous wound healing. It is hypothesized that the anti-inflammatory and antimicrobial properties of snail mucin, the anti-inflammatory characteristics of alginate, and the dressing capabilities of hydrogels may create a promising and effective combination for wound healing. Materials and MethodsMucin extraction from snails and preparationSnails used in this research were classified as Mollusca, Gastropoda, Stylommatophora, Familia Achatinidae, Achatina, and Achatina fulica. Adapted snails were kept in the new cages for 3 days, and a non-invasive electrical stimulation method was used to collect mucin according to a previous study (Rosanto et al., 2021). The snails were placed on a conductive plate after washing and cleaning them of any surface contamination. A 6–12 V electric shock (depending on the size and tolerance of the snails) was connected to the conductive metal plate for 60 seconds using two electrodes. Snails were encouraged to move on the plate for 10 minutes. This cycle was repeated 2–4 times, and the mucin was collected from the plate (Rosanto et al., 2021). The smallest bacteria, which are obligate intracellular pathogenic bacteria of the genus Mycoplasma, measure approximately 0.3 m in size (Chien et al., 2012). Mucin was passed through a 0.45-micrometer syringe filter and mixed with sodium carboxymethyl cellulose to form a gel with a mucin concentration of 96% (w/w, weight/weight) to reduce bacterial contaminants. A mucin concentration of 96% was used because the highest efficacy was observed by Rosanto et al., (2021) with this concentration. Notably, this extraction method is not harmful to snails. To determine the filter’s performance efficacy, the filtered mucin was cultured on Blood Agar and MacConkey Agar media. No bacterial growth was observed after 24 hours of incubation at 37°C. This process was performed in the Pathobiology Department of the Faculty of Veterinary Medicine, Shahid Bahonar University of Kerman, Iran (Fig. 1).
Fig. 1. Mucin filtration on the blood agar. Bacterial growth without a filter (A) and after filtering (B). No bacteria were observed after passing the mucin through the filter. Alginate hydrogel preparationAn ionically cross-linked alginate hydrogel, formed by ionic bridges within the polymer network, is dispersed with the surrounding medium via ion exchange of divalent ions (Sun and Tan, 2013). A hydrogel is immersed in CaCl2 solution, and Ca2+ ions are diffused from the outside to the hydrogel (diffusion method). An increase in Ca2+ concentration beyond the chelation threshold (>2.5 weight%) will significantly decrease the thermodynamic stability of alginate hydrogels. The rapid formation of an alginate–Ca2+ “egg-box” structure during CaCl2 diffusion makes it difficult to control the ionic cross-linking process (Zhang et al., 2020). Ionically cross-linked hydrogels exhibit pH-dependent swelling behavior because ionic crosslinking is a reversible process (Zhang and Zhao, 2020). Distilled water (1,000 ml) was poured into a beaker and maintained under standard laboratory conditions, specifically at room temperature and atmospheric pressure. For this, 20 g of sodium alginate was gradually added. The resulting dispersion was heated in a water bath at 100°C while being continuously stirred until the sodium alginate had fully dissolved, yielding a clear, homogeneous gel-like material. In a separate preparation, 25 g of anhydrous calcium chloride was dissolved in 1,000 ml of water in a second beaker under vigorous stirring to ensure complete dissolution. The sodium alginate (SA) solution was then introduced dropwise into the calcium chloride solution, which facilitated the ionic cross-linking process necessary to form separate SA hydrogel particles. These newly formed particles were allowed to stand undisturbed for 5 hours to ensure adequate gel maturation. Following this incubation period, the hydrogel particles were rinsed three times with distilled water to remove residual calcium ions and then immersed in fresh distilled water. This process resulted in the formation of sodium alginate hydrogel beads exhibiting particle sizes in the approximate range of 2–4 mm. The final product (alginate hydrogel) had a concentration of 2%. The extracted snail mucin was added to the alginate hydrogel at a 1:100 ratio (w/w) during magnetic stirring to prepare 1% mucin-containing alginate hydrogel (Al-Mu). Animals and preparation of groupsThis study used sixty rats; the sample size was calculated using an equation suitable for ANOVA studies. Sample calculation: Minimum n=10/k*r +1=10/(4 × 3) +1=1.83. Maximum n=20/k*r +1=20/(4 × 3) +1=2.66 (k=number of treatments, r=number of repeated measurements). Based on these calculations, three rats per group meet the sample size requirements. Rats were obtained from the animal house of Kerman University of Medical Sciences. Healthy male Wistar albino rats (2–3 months old, 200–300 g) were cage-adapted for 7 days. Animals had unrestricted access to food and water. Animals were randomly assigned to five experimental groups, with 12 rats in each group, as follows:
The no-treatment group served as a baseline for the natural wound-healing process, providing a comparison of the other treatment groups. Preparation of the wound siteRats were anesthetized with an intraperitoneal injection of ketamine Hydrochloric acid (HCl) (10%) at a dose of 50 mg/kg and xylazine HCl (2%) at a dose of 10 mg/kg to induce anesthesia and create a wound (Oktavia et al., 2025). The wound model used in this study was an excisional type, which is commonly employed in animal wound healing research (Dorsett-Martin and Wysocki, 2008). Following aseptic preparation (shaving and disinfecting with 5% povidone-iodine (scrub solution) and 70% alcohol), a full-thickness wound with a 1-cm diameter was created in the target area using a punch biopsy (the skin on the back of a rat) (Fig. 2). Meloxicam (2%, 1 mg/kg) was injected subcutaneously once a day for 3 days to reduce inflammation and pain caused by wound creation (Hedley, 2020).
Fig. 2. Gross appearance of cutaneous wounds in the different groups. Geometric evaluationDuring the study (21 days), the rate of wound closure was determined based on the reduction in the wound size using a camera with an “L” shaped scale ruler placed adjacent to the wound from a distance of 10 cm perpendicular to the wound site on days 0, 3, 7, 10, 14, and 21, and the wound area was then calculated using an image analysis program (ImageJ 1.52v software). Any reduction in the wound area indicates wound contraction and healing. The percentage of wound closure was calculated using the following equation (Moradi et al., 2023): Histopathological studiesOn days 7, 14, and 21, three rats from each group were humanely euthanized for microscopic investigation, and full-thickness skin samples (including both the wound area and adjacent healthy tissue) were harvested and immediately fixed with buffered formalin (10% in phosphate-buffered saline, 0.01 M, pH 7.4) and submitted to the pathology laboratory for histopathological evaluation. After processing (dehydration using alcohol and clearing in xylene) and embedding in paraffin, the tissues were sectioned to 5-μm thickness and stained by two staining methods: Hematoxylin and eosin (H&E) and Masson’s trichrome. The samples were then examined pathologically to assess inflammation (neutrophil infiltration, edema, and hyperemia), re-epithelialization, granulation tissue formation, collagen deposition, and scar maturation (Siahkouhi et al., 2023). Microscopic evaluations were performed at magnifications of 40 ×, 100 ×, and 400 × using a digital camera-equipped light microscope (Olympus, Tokyo, Japan). Scanning electron microscopyOn the final day of the study (day 21), three rats from each group were selected and euthanized for ultrastructural investigation. Full-thickness skin samples were dissected and processed following the combined techniques described by Ohtani (1987) and Yamamoto et al. (2004) with slight modifications. After fixation with 2.5% glutaraldehyde in 0.1 M phosphate buffer (pH 7.4) for 16–17 days at room temperature, the specimens were trimmed using a razor blade perpendicular to the surface. This exposed a cross-section from the marginal normal skin to the central granulation tissue for examination of all layers of the skin (Bahei-Eldin et al., 2017; Yamamoto et al., 2004). Subsequently, the tissues were rinsed with phosphate buffer and distilled water until the rinse became clear. Sections were then fixed in 1% osmium tetroxide (OsO4), immersed in a 1% aqueous solution of tannic acid overnight, rinsed in distilled water, and stained with 1% OsO4 for conductivity. They were dehydrated through a series of graded ethanol concentrations (with 30%, 50%, 70%, and 90% ethanol in sequential order) and were finally dehydrated twice in 100% ethanol (Kwan et al., 2011). The specimens were dried in a critical point dryer using liquid carbon dioxide. The dried specimens were mounted on scanning electron microscope specimen holders. A thin layer of gold metallic film was coated onto the dried specimens for 30 seconds using a plasma sputter before scanning electron microscopy (SEM) observation (Ohtani, 1987; Yamamoto et al., 2004). Observations were performed using a scanning electron microscope (TESCAN MIRA3 FE-SEM) with an accelerating voltage of 15 kV. Statistical analysisAll experiments were performed in triplicate (n=3) to ensure statistical analysis validity. The results were statistically analyzed using SPSS software (IBM SPSS Statistics, V.27, Armonk, New York) using paired-samples t-test and one-way analysis of variance test. Data are expressed as a mean ± standard error. The least significant difference (LSD) test was conducted to determine which groups showed significant differences. The results of histopathological studies were analyzed using nonparametric methods, including the Kruskal-Wallis H test and Mann–Whitney test. In all values, a p value of < 0.05 was considered statistically significant. Ethical approvalThe study was performed under review and guidelines by the Research Ethics Committee and standards for conducting Medical Research in Iran. The study was approved by the ethics committee of Veterinary Faculty of Shahid Bahonar University of Kerman. Approval ID: IR.UK.VETMED.REC.1400.017. ResultsComparison of the average wound area in ratsFig. 3 shows the changes in wound areas in rats on days 0, 3, 7, 10, 14, and 21 according to the different treatment groups and compounds used. Based on this figure, at the end of the 21st day, the wound of the mucin and Al-Mu groups (groups 4 and 5) was completely healed (0.00 ± 0.00 mm2). In rats treated with alginate hydrogel (group 3) (0.01 ± 0.00 mm2) and zinc oxide-treated (group 2) (0.03 ± 0.00 mm2), complete healing was not observed in two rats, and the average wound area was 0.22 ± 0.09 mm2 for no treatment (group 1).
Fig. 3. Comparison of the average wound area (cm2) in rats according to the studied compounds using the least significant difference method (95% probability level). Columns with the same letters for each day have no significant difference. Al-Mu in the figure refers to the mucin-containing aginate hydrogel group. Based on the results of one-way ANOVA/LSD (Table 1), for the average wound area during the 10th day (p=0.011), 14th day (p < 0.001), and 21st day (p=0.004), a significant difference was observed between different groups. However, there was no demonstrated notable variation in the average wound area between the study groups on the 3rd and 7th days (p > 0.05). The results of the LSD post hoc test (Fig. 3) showed that the average wound area in the rats of the mucin group on the 10th day was significantly less than that in the no-treatment (p < 0.001) and alginate hydrogel (p=0.007) groups. However, no significant difference was observed between the other groups. On the 14th day, the average wound area in the rats of the no-treatment group was significantly greater than that of the other groups (p < 0.001). On the 21st day, the same as on the 14th day, the average area of the wound in the rats of the no-treatment group was significantly more than the other groups and was different from zinc oxide-treated (p=0.004), alginate hydrogel (p=0.002), mucin (p < 0.001), and Al-Mu (p=0.001) groups. Fig. 2 shows the wound-healing process in the different groups. Table 1. Effect of Alginate Hydrogel, Mucin and Mucin-containing Alginate Hydrogel on wound area (cm2) on various days of healing in Rats.
Comparison of the average wound contraction percentage in ratsFig. 4 shows the changes in the percentage of wound contraction in rats treated with different compounds on days 0, 3, 7, 10, 14, and 21. According to this figure, the wounds in the groups that received mucin and Al-Mu were completely healed at the end of the 21st day and showed the highest average percentage of wound contraction (100.00% ± 0.00%). The alginate hydrogel group showed an average wound contraction percentage of 98.78% ± 0.87%, and the zinc oxide-treated group showed 95.38% ± 0.62%. The wounds of the two rats in each group were not completely healed. The lowest wound contraction percentage was observed in the no-treatment group (71.58% ± 9.49%).
Fig. 4. Comparison of the average percentage of wound contraction in rats according to the studied compounds with the LSD supplemental test (95% probability level). Columns with the same letters for each day have no significant difference. Al-Mu in the figure refers to the mucin-containing alginate hydrogel group. A one-way analysis of variance and the LSD post hoc test were used to investigate the difference in the average percentage of wound contraction of rats during the healing period and the studied compounds (Table 2). In the examination of the samples of all groups on the average percentage of wound contraction during the 7th day (p < 0.001), the 10th day (p=0.001), the 14th day (p < 0.001), and the 21st day (p=0.002), a significant difference was observed. On the 3rd day, there was no statistically significant improvement among the groups (p=0.387). Table 2. Effect of Alginate Hydrogel, Mucin and Mucin-containing Alginate Hydrogel on contraction of wound area (%) on various days of healing in rats.
The LSD post hoc test on day 7 (Fig. 4) showed that the average percentage of wound contraction was significantly higher in the Al-Mu group than in the no-treatment (p=0.005), zinc oxide-treated (p < 0.001), and alginate hydrogel groups (p=0.019). The average percentage of wound contraction in the rats of the mucin group was significantly higher than that in the no-treatment (p=0.038) and zinc oxide-treated (p < 0.001) groups. A significant difference was also observed between the zinc oxide-treated and the alginate hydrogel groups (p=0.035). No other significant differences were detected among the remaining groups (p > 0.05). On the 10th day, the LSD post hoc test (Fig. 4) showed that the average percentage of wound contraction in the mucin group was significantly higher than that in the no-treatment (p < 0.001), zinc oxide-treated (p=0.002), and alginate hydrogel groups (p=0.003). The average percentage of wound contraction was significantly higher in the Al-Mu group than in the no-treatment group (p=0.017). No other significant differences were detected among the remaining groups (p > 0.05). On the 14th day, the LSD post hoc test (Fig. 4) showed that the average percentage of wound contraction in the no-treatment group was remarkably lower than that in the groups treated with zinc oxide (p=0.002), alginate hydrogel, mucin, and Al-Mu (p < 0.001). In addition, there was a significant difference between the groups treated with zinc oxide and mucin (p=0.022). No other significant differences were detected among the remaining groups (p > 0.05). The LSD post hoc test on day 21 (Fig. 4) showed that the average percentage of wound contraction in the no-treatment group was significantly lower than that in the zinc oxide-treated (p=0.003), alginate hydrogel, mucin, and Al-Mu (p < 0.001) groups. No other notable differences were detected among the remaining groups (p > 0.05). Histopathological evaluationThe histopathological results on the 7th, 14th, and 21st days are presented in Tables 3, 4, and 5. Table 3. The effect of Alginate Hydrogel, Mucin and Mucin-containing Alginate Hydrogel on histological changes on day 7 of healing in rats. The data were expressed as Median (Minimum / Maximum).
Table 4. The effect of Alginate Hydrogel, Mucin and Mucin-containing Alginate Hydrogel on histological changes on day 14 of healing in rats. The data were expressed as Median (Minimum / Maximum).
Table 5. The effect of Alginate Hydrogel, Mucin and Mucin-containing Alginate Hydrogel on histological changes on day 21 of healing in rats. The data were expressed as Median (Minimum / Maximum).
According to the Kruskal-Wallis H test, on the 7th day among the studied groups, there was no significant difference in the amount of re-epithelialization (p=0.341), granulation tissue formation (p=0.198), and the presence of lymphocytes and macrophages (p=0.165). However, the results showed a significant difference in the amount of angiogenesis (p=0.039) and the presence of neutrophils (p=0.036). Analysis of angiogenesis data using the Mann–Whitney test revealed a significant difference between the no-treatment group and the groups treated with mucin (p=0.043) and Al-Mu (p=0.034). However, no notable variation was observed between the alginate hydrogel, mucin, and Al-Mu with the zinc oxide-treated group (p > 0.05). In the presence of neutrophils, there was a statistically significant difference between the mucin group with the no-treatment (p=0.034), the zinc oxide-treated (p=0.034), and the alginate hydrogel (p=0.025) groups. Also, there was a difference between the Al-Mu hydrogel group and the no-treatment group (p=0.034) and between the Al-Mu hydrogel group and the no-treatment group (p=0.034). However, there was no significant difference between the Al-Mu with the zinc oxide-treated, alginate hydrogel, and mucin groups (p > 0.05). According to the Kruskal-Wallis H test, on the 14th day, there was no significant improvement in the amount of angiogenesis among the studied groups (p=0.353). However, there was a significant difference in the amount of re-epithelialization (p=0.021), the maturation of granulation tissue (p=0.022), and the organization (p=0.048) among the studied groups. Mann–Whitney test revealed a significant difference in the amount of re-epithelialization between the no-treatment group and the groups treated with alginate hydrogel (p=0.043), mucin (p=0.043), and Al-Mu (p=0.043). There was also a significant difference between the zinc oxide-treated group and the groups treated with alginate hydrogel (p=0.034), mucin (p=0.034), and Al-Mu (p=0.034). There was a significant difference in granulation tissue maturation between the no-treatment group and the groups treated with mucin (p=0.043) and Al-Mu (p=0.034). There was also a significant difference between the zinc oxide-treated group and the groups treated with mucin (p=0.043) and Al-Mu (p=0.034). There was no difference in the amount of re-epithelialization and granulation tissue maturation between the treatment groups (p > 0.05). Data analysis using the Mann–Whitney test on the organization showed a significant difference between the no-treatment group and the mucin-treated group (p=0.043). On the 21st day, the results of the Kruskal-Wallis H test showed a significant difference in the amount of re-epithelialization (p=0.014) and organization (p=0.038); however, no significant improvement was observed in the amount of angiogenesis (p=0.051) and maturation of the granulation tissue (p=0.097) among the studied groups. A two-by-two comparison with the Mann–Whitney method showed a statistically significant difference in the amount of re-epithelialization between the no-treatment group with zinc oxide (p=0.034), alginate hydrogel (p=0.034), mucin (p=0.043), and Al-Mu (p=0.034). There was also a significant difference in the level between the Al-Mu group and the alginate hydrogel group (p=0.025). However, no significant difference was observed in the amount of re-epithelialization between the alginate hydrogel group and the zinc oxide-treated and mucin groups and between the zinc oxide-treated, mucin, and Al-Mu groups (p > 0.05). On the 21st day, there was a statistically significant difference in the organization between the no-treatment group and all other groups (p=0.034), but there was no difference among the other groups (p > 0.05). Wound healing processes in different groups on the 7th day are shown in Figure 5. According to this figure, a substantial amount of necrotic tissue can be observed in the no-treatment group (a), and the inflammatory phase remains ongoing. Re-epithelialization and granulation tissue formation are minimal. A crusty scab is also observed. In the zinc oxide-treated group (b) as well as in the treatment groups, re-epithelialization and granulation tissue are more advanced than those in the no-treatment group. As shown in Figure 5, the extracellular matrix (ECM) is more organized in the treatment groups, and epithelial proliferation initiates from the wound margins, particularly in the mucin (d) and Al-Mu (e) groups, which show better results than zinc oxide-treated (b) and alginate hydrogel (c) groups. Overall, the healing process is more advanced in the treatment and shows signs of progression into the wound healing proliferative phase.
Fig. 5. Histopathologic examination of wounds after 7 days. a, no treatment; b, zinc oxide treatment; c, alginate hydrogel; d, mucin; and e, Al-Mu. The mucin group (d) showed better healing processes, such as re-epithelialization (arrow) and granulation tissue quality, than the other treated and control groups. Neutrophilic exudate (arrowhead) is observed on the surface of some wounds (hematoxylin and eosin staining). Figure 6 shows the wound healing process on day 14. Re-epithelialization remains limited near the wound margins in the no-treatment group (a). Immature granulation tissue with minimal collagen deposition is also observed beneath the scab. Granulation tissue is more developed in the zinc oxide-treated group (b), with signs of early collagen synthesis in deeper layers, although the superficial areas still contain immature granulation tissue. Partial re-epithelialization is evident. In the treatment groups (c, d, and e), a high percentage of the wound surface was covered with new epidermis. The maturation of the granulation tissue in the treatment groups (c, d, and e) is more advanced than that in the zinc oxide-treated group. Figure 6 shows that the cellularity, particularly fibrocytes, is noticeably reduced in the treatment groups (c, d, and e) compared to the no-treatment group, and the ECM is well organized. Collectively, these findings suggest that the remodeling phase has commenced in the treatment groups, i.e., alginate hydrogel (c), mucin (d), and Al-Mu (e), indicating enhanced tissue regeneration. The collagen deposition was also greater than that observed in the zinc oxide-treated group. Among all groups, collagen deposition was highest in the Al-Mu group (e), and the ECM was similarly organized as in the mucin group (d).
Fig. 6. Histopathologic figure of the control and treated wounds after 14 days. a: no treatment, b: zinc oxide treatment, c: alginate hydrogel, d: mucin, and e: Al-Mu groups. In the wound treated with snail mucin (d), the healing tissue showed more organization and a higher number of fibrocytes (open arrows) compared with the alginate hydrogel group (c) with more fibroblasts (thick arrows), and Al-Mu and positive groups with vertical orientation of new vessels (arrowheads). Re-epithelialization (thin arrow) is complete. The circle indicates more inflammatory cell infiltration in groups (a) and (e). (HE staining, scale bar=100 in b; and 10 µm in a, c, d, e). Collagen deposition (indicated by the green color) during wound healing on the 14th day in different treatment groups is shown in Fig. 7. In the no-treatment group (a), collagen deposition is minimal compared with the other groups, with an incomplete ECM. In contrast, the mucin (d) and Al-Mu (e) groups exhibited a greater quantity of collagen fibers, more extensive collagen deposition, and superior fiber alignment compared with the alginate hydrogel (c) and zinc oxide-treated (b) groups.
Fig. 7. This photomicrograph shows the healing processes of the wounds in different groups after 14 days. a: no treatment, b: zinc oxide treatment, c: alginate hydrogel, d: mucin, and e: Al-Mu groups. The intense green color is related to collagen maturation, which is considerable in Figure (d). (Masson’s Trichrome staining, Scale Bar=50 µm). Healing processes in the wounds of the different groups on the 21st day are illustrated in Figure 8. In the no-treatment group (a), a large amount of immature granulation tissue with high cellularity and limited collagen synthesis is evident. Although collagen deposition has improved compared to day 14, the remodeling phase remains incomplete. Complete re-epithelialization is observed in the treatment groups (c, d, and e). The dermis exhibited mature granulation tissue with reduced angiogenesis and well-organized collagen bundles. The healing pattern in the zinc oxide-treated group (b) is comparable to that of the treatment groups. In the alginate hydrogel group (c), re-epithelialization is nearly complete, similar to that in the zinc oxide-treated group (b). Granulation tissue in the superficial part of the dermis remains immature. The dermis in the zinc oxide-treated (b), mucin-treated (d), and Al-Mu-treated (e) groups appears well-structured, and the healing processes in groups d and e appear to be complete.
Fig. 8. This photomicrograph shows the healing processes of the wounds after 21 days. a: no treatment, b: zinc oxide treatment, c: alginate hydrogel, d: mucin, and e: Al-Mu groups. Re-epithelialization (arrow) does not cover the wound surface in the alginate hydrogel group (c). and maturation in (a) and (c) groups are lower than those in (b), (d), and (e). Some new vessels with vertical orientation are still present (arrowheads). (HE staining, Scale Bar=10 µm). Figure 9 illustrates collagen deposition (denoted by the green color) during wound healing on the 21st day across various treatment groups. Collagen deposition in the no-treatment group (a) improved compared with that on day 14 (Fig. 7), with the ECM entering the remodeling phase. The amount of collagen deposition remained minimal compared with the other groups, which shows a slower and less effective wound healing process in the control group. In contrast, the mucin (d) and Al-Mu (e) groups exhibited a greater presence of collagen bundles, more extensive collagen deposition, and significantly better collagen fiber alignment compared with the alginate hydrogel (c) and zinc oxide-treated (b) groups. This increased collagen deposition and enhanced fiber orientation may indicate a more efficient healing process, which could lead to faster recovery and better tissue regeneration. Furthermore, the healing process in the mucin (d) and Al-Mu (e) groups appeared nearly complete, with tissue structure and organization closely resembling that of normal skin, as shown in the figure.
Fig. 9. This photomicrograph shows the healing processes of the wounds after 21 days. a: no treatment, b: zinc oxide treatment, c: alginate hydrogel, d: mucin, and e: Al-Mu groups. The wounds treated with mucin (d) and Al-Mu (e) have a more intensive green color related to collagen maturation compared with the other groups (Masson’s Trichrome staining, Scale Bar=50 µm). The SEM analysis of wound healing on the 21st day shows that the best healing effect among various treatments was observed in wounds treated with mucin (d) and Al-Mu (e), demonstrating rapid regeneration and maturation of the new epidermis. In contrast, incomplete re-epithelialization was observed in the no-treatment (a) and alginate hydrogel (c) groups. The zinc oxide-treated group (b) showed immature re-epithelialization at the wound center (Fig. 10).
Fig. 10. SEM photomicrograph shows healing processes of the wounds in different experimental groups on the 21st day. a: no treatment, b: zinc oxide treatment, c: alginate hydrogel, d: mucin, and e: Al-Mu groups. Re-epithelialization is marked by an arrowhead. Asterisk (a) shows irregularity of collagen fibers in the dermis of the wound area, and the circle is used for better organization of healing tissue in the alginate hydrogel group (d). Magnification: 100x. Fig. 11 presents a detailed SEM analysis (10,000 × magnification) of the organization of collagen fibers across the different treatment groups on day 21. In the no-treatment group (a), collagen fibers appeared disorganized and oriented in multiple directions, indicating poor connective tissue structural remodeling. In contrast, the mucin (d) and Al-Mu (e) groups demonstrated more organized connective tissue and a better-aligned collagen fiber network compared with the other groups. In these groups, collagen fibers were largely parallel and formed compact bundles, reflecting the advanced stages of tissue repair. The Al-Mu group (e) showed near-complete healing and optimal tissue repair. Among all treated groups (c, d, and e), the alginate hydrogel group (c) exhibited the least collagen continuity, bundle formation, and organization. Although the zinc oxide-treated group (b) showed better alignment than the no treatment group (a), its collagen organization was still inferior to that observed in the mucin-based treatments.
Fig. 11. SEM photomicrograph shows healing processes of the wounds in different groups on the 21st day. a: no treatment, b: zinc oxide-treated, c: alginate hydrogel, d: mucin, and e: Al-Mu groups. Magnification: 10 kx. DiscussionNatural mucus has recently presented important benefits in medicine, cosmetics, and the food industry. This study demonstrates the effects of the giant African snail mucin and alginate hydrogel on cutaneous wound healing after three weeks of treatment. All five groups were evaluated by histopathology, light, and SEM. Although many natural or synthetic components are utilized to reduce the wound healing convalescence period, the snail mucin used in diabetic wounds (DW) shows accelerated healing in DW healing (Mishra et al., 2025). Interestingly, the slime extracted from A. fulica has been reported to heal incised wounds faster than self-healing (Wiya et al., 2020). According to a study, using a dried mucus-based scaffold has distinct wound closure at day 10, and H&E staining additionally demonstrated considerable neo-tissue infiltration, which signifies the breakdown of scaffolds three weeks after implantation (Yuan et al., 2025). In another study, A. fulica mucin (slime extract) during treatment compared with human placental extract showed a promising natural remedy for wound healing (Pranandi et al., 2025). Peng et al. (2025) believe that biomacromolecules in natural mucus, including chitosan, hyaluronic acid, dextran, fibrin, elastin, and alginate, are an adhesive complex that constructs covalent and non-covalent interactions that exhibit significant potential as a substitute for wound healing (Peng et al., 2025). Snail mucin has been reported to have pharmacological activities, including antibacterial activity, antioxidant and regenerative properties, anti-inflammatory activity, and anticancer properties (Zhu et al., 2024). Generally, the use of chemicals and antibiotics to treat and prevent wound infection may cause sensitivity, toxicity to the host, and the spread of antibiotic resistance in microorganisms. Therefore, the use of plant compounds as natural substances can be a method to prevent harmful side effects (Elsner et al., 2010; Khaledi et al., 2020). Recently, alginate-based materials and their derivatives have attracted great attention because they have shown great significance in biomedical applications (Manjula et al., 2013). Alginate has been used to develop novel wound healing and smart biomaterials due to its various functionalities, such as reducing swelling, non-toxicity, biocompatibility, antimicrobial potential, and ability to absorb wound fluid and promote skin regeneration. The unique properties of hydrogels, such as hydrophilic nature, soft tissue-like content, high sensitivity to physiological environments, and adequate flexibility, have made them the preferred and excellent choice for wound healing-related therapeutics (Kibungu et al., 2021). This research represents the use of mucin and alginate hydrogel on cutaneous wound healing and declares that no significant difference was observed between the mucin and Al-Mu groups. This indicates that the alginate- and mucin-containing hydrogel has a promising effect. Angiogenesis stimulation starts with TNF-α, which is determined by endothelial cell migration and capillary formation. The lower number of neutrophils in the mucin and Al-Mu groups than in the control groups on day 7 reflects the effectiveness of snail mucin in speeding up the inflammation stage of wound healing. On day 7, the wound area contraction (%) in the negative and zinc oxide-treated groups was significantly lower than that in the mucin and Al-Mu groups. These findings are consistent with those of previous studies and confirm the role of snail mucin in vascularization promotion (Rahmawati et al., 2014; Harti et al., 2016; Dhiman and Pant, 2021; Rosanto et al., 2021). Based on our study, especially on the 14th day, and other research, wound healing is directly related to the formation of new vessels, and the groups treated with mucin had a higher rate of angiogenesis and transition of the wound from the inflammatory phase to the proliferative phase (Oryan et al., 2012; Sun et al., 2024). Additionally, the presence of HA in snail mucin contributes to ECM modulation, facilitating cell migration and providing structural support for the formation of granulation tissue. It may also mimic the activity of growth factors, such as vascular endothelial growth factor, which can be attributed to the development of granulation tissue (Durant and Whited, 2021; Deng et al., 2023). The percentage of wound contraction was significantly lower in the no-treatment group than in all other groups. The effectiveness of alginate and snail mucin in wound healing and their preparation as hydrogels in this study was corroborated by previous research (Harti et al., 2016; Ehterami et al., 2019; Bagher et al., 2020; Ezealisiji Kenneth et al., 2020). After 21 days, there was a significant difference in the amount of re-epithelialization and ECM organization between the no-treatment group and all other groups. Therefore, the increase in collagen deposition and its organization in the wound may be due to the reduction of inflammatory reactions or the organization of the fibrin network, which may be induced by the effects of snail mucin extract, as demonstrated in the SEM images of the mucin and Al-Mu groups on day 21 (Singh et al., 2024; Mishra et al., 2025). On day 14, the formation and rearrangement of epithelial tissue in the treatment groups were significantly different from those in the control groups. The zinc oxide and treatment groups were significantly different from the no-treatment group on day 21. No significant difference was observed between the zinc oxide group and the treatment group. This indicates that mucin and alginate hydrogel have the same effect as zinc oxide ointment. The difference in the amount of re-epithelialization between the alginate hydrogel group and the Al-Mu group on day 21 indicates that the extracted snail mucin can improve the healing properties of the alginate hydrogel. Based on the results of this study on day 21, the percentage of wound area contraction (%) in the no-treatment group was significantly lower than that in the groups treated with alginate, mucin, Al-Mu, and zinc oxide. The results of this study are consistent with previous findings and confirm the effectiveness of snail mucin and alginate hydrogel in improving wound healing. These treatments may be as effective as zinc oxide. ConclusionIn conclusion, A. fulica snail mucin extract demonstrated significant effects on wound healing, wound contraction, inflammation reduction, and angiogenesis enhancement. Additionally, hydrogels provide an optimal environment for tissue regeneration because of their moisture-retaining and biocompatible properties. The combination of A. fulica mucin with biodegradable carriers, such as alginate hydrogel, further enhances its therapeutic efficacy. Mucin-based hydrogel can be used as a natural and biological compound for treating wounds. This procedure offers that in addition to the 1:100 ratio, other ratios should be used in future studies to assess the efficacy of wound healing across different ratios. AcknowledgmentsNone. Conflict of interestThe authors declare no conflict of interest. FundingNo specific grant was received for this research from any funding agency in the public, commercial, or not-for-profit sectors. This study received no funding. Authors' contributionMRS applied all clinical works such as surgical procedures, treatment group management, MMM writing drafts, supervision, edition of manuscripts, SA histopathologic assessments, reviewing the article, analysis and interpretation of data, PM acquisition of data, conception and design, MJ final approval, drafting the data, and investigations. Data availabilityAll data were provided in the manuscript. ReferencesBagher, Z., Ehterami, A., Safdel, M.H., Khastar, H., Semiari, H., Asefnejad, A., Davachi, S.M., Mirzaii, M. and Salehi, M. 2020. Wound healing with alginate/chitosan hydrogel containing hesperidin in rat model. J. Drug Deliv. Sci. Technol. 55, 101379. Bahei-Eldin, I., Elgazzar, M., Ahmed, A. and Mohamed, S. 2017. Effect of spirulina extract on skin wound healing in adult albino rats: a light and scanning electron microscopic study. Egypt. J. Anatology. 40(1), 33–53. Bernabe, J.R., Aggabao, M.J.D., Roderos, A.J.J., Gabriel, E.M.A., Bantigue, P.C. and Guinto, A.M. 2023. Efficacy of snail mucin in wound healing: a review. J. Jilin Univ. 42(6), 64–80. Chen, J.P., Hong, L., Wu, S. and Wang, L. 2002. Elucidation of interactions between metal ions and Ca alginate-based ion-exchange resin by spectroscopic analysis and modeling simulation. Langmuir 18(24), 9413–9421; doi:10.1016/j.langmuir.2018.09.013 Chien, A.C., Hill, N.S. and Levin, P.A. 2012. Control of cell size in bacteria. Curr. Biol. 22(9), R340–R349. Das, P.P.G., Bhattacharyya, B., Bhagawati, S., Nath, J.D. and Sarmah, K. 2022. Methods of mucin extraction from the giant African snail Achatina fulica Bowdich. Indian J. Entomol. 84(2), 296–300. Deng, T., Gao, D., Song, X., Zhou, Z., Zhou, L., Tao, M., Jiang, Z., Yang, L., Luo, L. and Zhou, A. 2023. Natural biological adhesive from snail mucus for wound repair. Nature Commun. 14(1), 396. Dhiman, V. and Pant, D. 2021. Human health and snails. J. Immunochem. 42(3), 211–235. Dorsett-Martin, W.A. and Wysocki, A.B. 2008. Rat models of wound healing in the skin. In Michael Conn, P. (eds), Sourcebook of Models for Biomedical Research. Totowa, NJ: Humana Press, pp: 631–638. Durant, F. and Whited, J.L. 2021. Finding solutions for fibrosis: understanding the innate mechanisms used by super-regenerator vertebrates to combat scarring. Adv. Sci. 8(15), 2100407. Ehterami, A., Salehi, M., Farzamfar, S., Samadian, H., Vaez, A., Ghorbani, S., Ai, J. and Sahrapeyma, H. 2019. Chitosan/alginate hydrogels containing alpha-tocopherol for wound healing in rat model. J. Drug Deliv. Sci. Technol. 51, 204–213. Elsner, J.J., Shefy-Peleg, A. and Zilberman, M. 2010. Novel biodegradable composite wound dressings with controlled release of antibiotics: microstructure, mechanical and physical properties. J. Biomedic. Mater. Res. Part B. Appl. Biomat. 93(2), 425–435. Etim, L., Aleruchi, C. and Obande, G. 2016. Antibacterial properties of snail mucus on bacteria isolated from patients with wound infection. Br. Microbiol. Res. J. 11(2), 1–9. Ezealisiji, K.M., Chidiebere, O. and Siwe-Noudou, X. 2020. Novel zinc oxide nano-hydrogel and mucin co-formulation for diabetic wound healing: a synergistic approach. Eur. J. Pharm. Med. Res. 7(9), 93–100. Francesko, A., Petkova, P. and Tzanov, T. 2018. Hydrogel dressings for advanced wound management. Curr. Med. Chem. 25(41), 5782–5797. Harti, A.S., Sulisetyawati, S.D., Murharyati, A., Oktariani, M. and Wijayanti, I.B. 2016. The effectiveness of snail slime and chitosan in wound healing. Intern. J. Phar. Med. Biol. Sci. 5(1), 76. Hedley , J. 2020. BSAVA small animal formulary part B: exotic pets. Gloucester, UK: British Small Animal Veterinary Association, pp: 194–195. Khaledi, M., Bagheri, N., Validi, M., Zamanzad, B., Afkhami, H., Fathi, J., Rahimian, G. and Gholipour, A. 2020. Determination of the CagA EPIYA motif in H. pylori strains isolated from patients with digestive disorders. Heliyon 6(9), e04971. Kibungu, C., Kondiah, P.P., Kumar, P. and Choonara, Y.E. 2021. Recent advances in chitosan and alginate-based hydrogels for wound healing applications are reviewed. Front. Mater. 8, 681960. Kuo, C.K. and Ma, P.X. 2008. Maintaining dimensions and mechanical properties of ionically crosslinked alginate hydrogel scaffolds in vitro. J. Biomed. Mater. Res. Part A. 84(4), 899–907. Kwan, K.H.L., Liu, X., To, M.K.T., Yeung, K.W.K., Ho, C.M. and Wong, K.K.Y. 2011. Modulation of collagen alignment by silver nanoparticles results in better mechanical properties in wound healing. Nanomed. Nanotechnol. Biolo. Med. 7(4), 497–504. Manjula, B., Varaprasad, K., Sadiku, R. and Raju, K.M. 2013. Preparation and characterization of sodium alginate–based hydrogels and their in vitro release. Adv. Polym. Technol. 32(2), 21340. Mishra, R., Singh, T.G., Bhatia, R. and Awasthi, A. 2025. Unveiling the therapeutic journey of snail mucus in diabetic wound care. Naunyn-Schmiedeberg's. Archi. Pharmacol.398(6), 6531–6560.. Moradi, M., Sabiza, S., Rezaie, A. and Ezzati-Givi, M. 2023. Effect of pentoxifylline and zinc oxide combination on experimental full-thickness wound healing in rats. Iran. J. Vet. Surg. 18(1), 8–17. Ohtani, O. 1987. Three-dimensional organization of connective tissue fibers of the human pancreas: a scanning electron microscopic study of NaOH-treated tissues. Archivum Histological. Japonicum 50(5), 557–566. Oktavia, N.S., Mustika, A. and Hidayati, A.N. 2025. Mechanism of the effect of Piper crocatum extract on wound healing in Wistar rats after mammary tumor excision based on IL-10 level, TGF-β1 expression, VEGF expression, collagen density, and clinical features. Open Vet. J. 15(3), 1264. Oliveira Jr, L.A.T., Souza, V.R., Endringer, D.C., Hendrickson, D.A. and Coelho, C.S. 2012. Effects of topical application of sunflower-seed oil on experimentally induced wounds in horses. J. Vet. Sci. 32, 139–145. Oryan, A., Naeini, A.T., Moshiri, A., Mohammadalipour, A. and Tabandeh, M.R. 2012. Modulation of cutaneous wound healing by silymarin in rats. J. Wound Care 21(9), 457–464. Peng, X., Wang, Z., Wang, L. and Hou, W. 2025. Mucus-derived biomaterial dressings: a novel approach to accelerate wound healing. Theranostics 24:15(16), 8068. Pranandi, I., Tanjung, J.R. and Novi Handayani, M.D. 2025. Snail (Achatina fulica) slime extract effectively increases the healing speed of incised wounds. Front. Heal. Inf. 1(14 1), 1. Rahmawati, F., Mayasari, D.A., Adhitioso, S., Putra, A.P., Kuntjoro, E.B. and Widiyanti, P. 2014. Utilization of A. fulica mucus in alginate membrane as a wound healing accelerator and anti-infection material. Indo. J. Tropic. Infect. Dis. 5(1), 12. Rosanto, Y.B., Hasan, C.Y., Rahardjo, R. and Pangestiningsih, T.W. 2021. Effect of snail mucus on angiogenesis during wound healing. F1000Research 10, 181. Siahkouhi, H.R., Molaei, M.M., Sakhaee, E., Kheirandish, R. and Mohammadi, P. 2023. Hydrogel Based on Alginate-Polyethylene Glycol Polymer Containing Scrophularia striata Extract Nano-Liposomes is an Excellent Nano-Phyto-Extract in Wound Healing; a Geometric and Pathological Study. J. Vet. Surg. 18, 46–59. Singh, N., Brown, A.N. and Gold, M.H. 2024. Snail extract for skin: a review of uses, projections, and limitations. J. Cos. Dermatol. 23(4), 1113–1121. Sivamani, R.K., Ma, B.R., Wehrli, L.N. and Maverakis, E. 2012. Phytochemicals and naturally derived substances for wound healing. Adv. Wound Care 1(5), 213–217. Sun, J. and Tan, H. 2013. Alginate-based biomaterials for regenerative medicine applications. Materials 6(4), 1285–1309. Sun, L., Wang, X., Deng, T., Luo, L., Lin, L., Yang, L., Tian, Y., Tian, Y. and Wu, M. 2019. Bionic sulfated glycosaminoglycan-based hydrogel inspired by snail mucus promotes diabetic chronic wound healing via regulating macrophage polarization. Inter. J. Biol. Macromol. 281, 135708. Thomas, A., Harding, K. and Moore, K. 2000. Alginates from wound dressings activate human macrophages to secrete tumor necrosis factor-α. Biomat 21(17), 1797–1802. Van Der Laan, A.M., Piek, J.J. and Van Royen, N. 2009. Targeting angiogenesis to restore microcirculation after reperfused MI. Nature Rev. Cardiol. 6(8), 515–523. Varaprasad, K., Jayaramudu, T., Kanikireddy, V., Toro, C. and Sadiku, E.R. 2020. Alginate-based composite materials for wound dressing application: a mini review. Carbohydropolymers 236, 116025. Wiya, C., Nantarat, N. and Saenphet, K. 2020. Anti-inflammatory activity of slime extract from giant African snail (Lissachatina fulica) Indi. J. Pharma. Sci. 82(3), e01313. Yamamoto, N., Kiyosawa, T., Arai, K. and Nakayama, Y. 2004. Dermal neoformation during skin wound healing as demonstrated using scanning electron microscopy. Ann. Plastic Surg. 52(4), 398–406. Yang, D. and Jones, K.S. 2009. Effect of alginate on innate immune activation of macrophages. J. Biomed. Mater. Res. Part A. 90(2), 411–418. Yoshii, F., Zhanshan, Y., Isobe, K., Shinozaki, K. and Makuuchi, K. 1999. Electron beam crosslinked PEO and PEO/PVA hydrogels for wound dressing. Radia. Phys. Chem. 55, 133–138. Yuan Z Wu., Fu, S., Wang, L., Wang, X., Shafiq, Z., Feng, M., Han, H., Song, L., El, J. and -Newehy M Abdulhameed. 2025. Natural biological adhesive from slug mucus for wound repair. Bioactive Mater. 1(47), 513–527. Zhang, C., Grossier, R., Candoni, N. and Veesler, S. 2021. Preparation of alginate hydrogel microparticles by gelation introducing cross-linkers using droplet-based microfluidics: a review of methods. Biomat. Res. 25, 41; doi:10.1016/j.biomat.2011.01.013 Zhang, H., Cheng, J. and Ao, Q. 2021. Preparation of alginate-based biomaterials and their biomedical applications. Mar. Drugs 19(5), 264. Zhang, M. and Zhao, X. 2020. Alginate hydrogel dressings for advanced wound management. Int. J. Biol. Macromol. 162, 1414–1428. Zhang, X., Wang, K., Hu, J., Zhang, Y., Dai, Y. and Xia, F. 2020. Role of a high calcium ion content in extending the properties of alginate dual-crosslinked hydrogels. J. Mater. Chem. A 8(47), 25390–25401. Zhu, K., Zhang, Z., Li, G., Sun, J., Gu, T., Ain, N.U., Zhang, X. and Li, D. 2024. Extraction, structure, pharmacological activities and applications of polysaccharides and proteins isolated from snail mucus. Inter. J. Biol. Macromol. 258(1), 128878; doi:10.1016/j.ijbma.2018.09.008 | ||
| How to Cite this Article |
| Pubmed Style Salahi MR, Molaei MM, Azizi S, Mohammadi P, Jajarmi M. Histopathological and ultrastructural evaluations of giant African snail (Achatina fulica) mucin and alginate hydrogel on cutaneous wound healing in rats. Open Vet. J.. 2025; 15(10): 5202-5220. doi:10.5455/OVJ.2025.v15.i10.37 Web Style Salahi MR, Molaei MM, Azizi S, Mohammadi P, Jajarmi M. Histopathological and ultrastructural evaluations of giant African snail (Achatina fulica) mucin and alginate hydrogel on cutaneous wound healing in rats. https://www.openveterinaryjournal.com/?mno=267986 [Access: January 25, 2026]. doi:10.5455/OVJ.2025.v15.i10.37 AMA (American Medical Association) Style Salahi MR, Molaei MM, Azizi S, Mohammadi P, Jajarmi M. Histopathological and ultrastructural evaluations of giant African snail (Achatina fulica) mucin and alginate hydrogel on cutaneous wound healing in rats. Open Vet. J.. 2025; 15(10): 5202-5220. doi:10.5455/OVJ.2025.v15.i10.37 Vancouver/ICMJE Style Salahi MR, Molaei MM, Azizi S, Mohammadi P, Jajarmi M. Histopathological and ultrastructural evaluations of giant African snail (Achatina fulica) mucin and alginate hydrogel on cutaneous wound healing in rats. Open Vet. J.. (2025), [cited January 25, 2026]; 15(10): 5202-5220. doi:10.5455/OVJ.2025.v15.i10.37 Harvard Style Salahi, M. R., Molaei, . M. M., Azizi, . S., Mohammadi, . P. & Jajarmi, . M. (2025) Histopathological and ultrastructural evaluations of giant African snail (Achatina fulica) mucin and alginate hydrogel on cutaneous wound healing in rats. Open Vet. J., 15 (10), 5202-5220. doi:10.5455/OVJ.2025.v15.i10.37 Turabian Style Salahi, Mohammad Reza, Mohammad Mahdi Molaei, Shahrzad Azizi, Pourya Mohammadi, and Maziar Jajarmi. 2025. Histopathological and ultrastructural evaluations of giant African snail (Achatina fulica) mucin and alginate hydrogel on cutaneous wound healing in rats. Open Veterinary Journal, 15 (10), 5202-5220. doi:10.5455/OVJ.2025.v15.i10.37 Chicago Style Salahi, Mohammad Reza, Mohammad Mahdi Molaei, Shahrzad Azizi, Pourya Mohammadi, and Maziar Jajarmi. "Histopathological and ultrastructural evaluations of giant African snail (Achatina fulica) mucin and alginate hydrogel on cutaneous wound healing in rats." Open Veterinary Journal 15 (2025), 5202-5220. doi:10.5455/OVJ.2025.v15.i10.37 MLA (The Modern Language Association) Style Salahi, Mohammad Reza, Mohammad Mahdi Molaei, Shahrzad Azizi, Pourya Mohammadi, and Maziar Jajarmi. "Histopathological and ultrastructural evaluations of giant African snail (Achatina fulica) mucin and alginate hydrogel on cutaneous wound healing in rats." Open Veterinary Journal 15.10 (2025), 5202-5220. Print. doi:10.5455/OVJ.2025.v15.i10.37 APA (American Psychological Association) Style Salahi, M. R., Molaei, . M. M., Azizi, . S., Mohammadi, . P. & Jajarmi, . M. (2025) Histopathological and ultrastructural evaluations of giant African snail (Achatina fulica) mucin and alginate hydrogel on cutaneous wound healing in rats. Open Veterinary Journal, 15 (10), 5202-5220. doi:10.5455/OVJ.2025.v15.i10.37 |